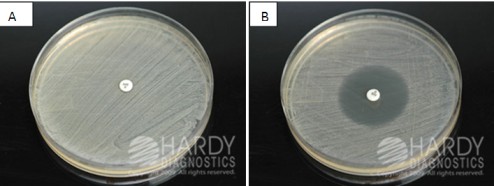
- Novobiocin sensitivity testing A. Novobiocin-resistant(S. saprophyticus)B. Novobiocin Sensitive(S. epidermidis)

Novobiocin test is used to differentiate coagulase-negative staphylococci (CONS) and presumptively identify the isolate as Staphylococcus saprophyticus  (novobiocin resistant).  It is usually performed on CONS isolated from a urine sample of women of a reproductive age group.

Principle of Novobiocin Test
S. saprophyticus is second only to E. coli as the most frequent causative organism of uncomplicated urinary tract infections (UTIs) in young sexually active women.  So when an organism that looks like staphylococci is isolated from a woman of reproductive age coagulase test is done. If the organism is coagulase-negative i.e. CONS the laboratory must further identify that isolate and find out if this is a true pathogen (Staphylococcus saprophyticus-novobiocin resistant) or a contaminant (i.e. Staphylococcus epidermidis-novobiocin sensitive).
Mneomonic:On the office’s STAPH retreat, there was NO StRESs. (NO=novobiocin, S=Saprophyticus, R=Resistant, E=Epidermidis, S=Sensitive
Laboratory identification of S. saprophyticus is made on the basis of the absence of hemolysis, coagulase, and resistance to novobiocin. Novobiocin susceptibility test results are 100% sensitive and 96% speci*fic. S. saprophyticus is innately resistant to the antibiotic novobiocin.*Therefore, screening coagulase-negative staphylococci from urine cultures for novobiocin resistance is reliable presumptive identification of S. saprophyticus.
Test organism
- Testing should be performed on isolated colonies of gram-positive cocci in clusters that are catalase-positive and coagulase-negative isolated from urine specimens, usually from sexually active young women.
- All colonies should be taken from a blood agar plate and growth must be less than 24 Â hours old, 15-18 hours being optimal.
Procedure of Novobiocin test
- Allow containers to come to room temperature before use.
- Using a pure 18-24 hour culture, prepare a suspension of the organism; equivalent to a McFarland 0.5 opacity standard; to be identified in tryptic soy broth, sterile water, Â or brain heart infusion (BHI) broth
- Inoculate Mueller Hinton Agar, 5% blood agar, or tryptic soy agar plate with a sterile swab to obtain confluent growth.
- Aseptically apply one 5ug novobiocin disk onto the inoculated agar surface and lightly press down to ensure full contact with the medium.
- Incubate plate aerobically for 18 to 24 hours at 35 to 37°C.
- Measure (in millimeters) the diameter of the zone of inhibition around the novobiocin disk, and record it as susceptible or resistant.
****Interpretation of Novobiocin test
- Resistant – zone size of < 12 mm
- Sensitive – zone size greater or equal to 16 mm.
Expected results:
- Staphylococcus saprophyticus – growth < 12mm or uniform growth up to the edge of the disk
- Staphylococcus epidermidis – Zone of inhibition >16 mm or larger
Quality Control
Quality control of novobiocin test should be performed per lot/shipment date with known organisms.
- Positive control (resistant) = Staphylococcus saprophyticus  (ATCC® 15305)
- Negative control (sensitive) = Staphylococcus epidermidis (ATCC® 12228)
Limitation
The novobiocin disk is not helpful and can give misleading results if it is performed on isolates other than those from urinary specimens. Occasional human isolates that are not S. saprophyticus, S. cohnii subsp., or S. xylosis may also be resistant to novobiocin.
References
- Afanas’eva, T. I., Shcherbakova, N. A., Givental’, N. I., & Bogdanova, L. F. (1979). Znachenie opredeleniia chuvstvitel’nosti k novobiotsinu v taksonomii stafilokokkov [Significance of determining novobiocin sensitivity in the taxonomy of staphylococci]. Antibiotiki, 24(11), 824–827.
- Leighton, P. M., & White, M. (1983). Rapid determination of novobiocin susceptibility for the identification of Staphylococcus saprophyticus. Diagnostic microbiology and infectious disease, 1(3), 261–264. https://doi.org/10.1016/0732-8893(83)90026-3